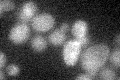
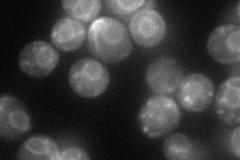

View description
Chitin synthase III, catalyzes the transfer of N-acetylglucosamine (GlcNAc) to chitin; required for synthesis of the majority of cell wall chitin, the chitin ring during bud emergence, and spore wall chitosan
Localization:
Intensity:
Fold change:
Significance:
-
C’ GFP library in SD
below threshold13.4 -
N' NOP1pr-GFP in SD
ER75.2008 -
N' TEF2pr-mCherry in SD

ER72.1523 -
N' NATIVEpr-GFP in SD

punctate,bud neck33.2269 -
N' TEF2pr-VC and Cyto-VN in SD

ER36.3717 -
C’ GFP library in SD+DTT

cytosol16.71.24No -
C’ GFP library in SD+H2O2

cytosol16.581.23No -
C’ GFP library in Starvation Media

cytosol15.221.13No -
C’ GFP library on the background of Pup2-DaMP

below threshold -
C’ GFP library on the background of CCT mutant

below threshold13.47971.00549No
